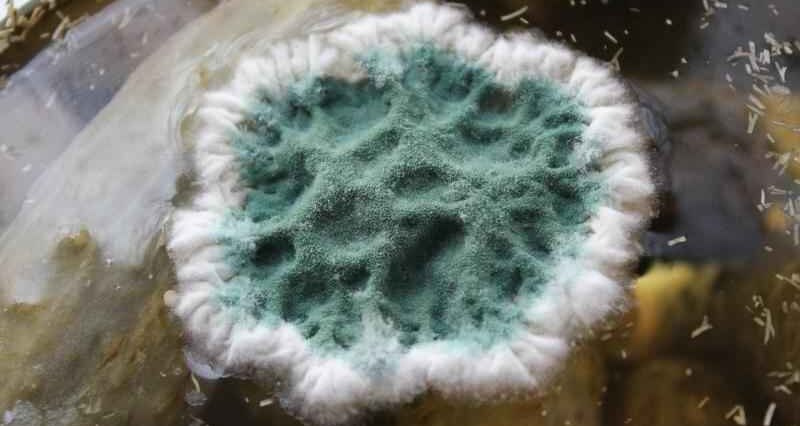

В морской плесени нашли вещество, защищающее от химических токсинов
Биологически активные соединения из морского плесневого гриба Penicillium dimorphosporum защищают клетки от высокотоксичного гербицида параквата, против которого нет противоядия, и, возможно, способны усиливать действие некоторых лекарств. Гриб выделен из мягкого коралла, собранного в Южно-Китайском море во время экспедиции на научно-исследовательском судне «Академик Опарин».
Паракват – высокотоксичное для животных и человека соединение-гербицид. Около сотни стран, в том числе США, используют его для обработки посевов и борьбы с сорняками. В десятках стран, включая Россию, использовать ядовитое соединение запрещено. Проблема отравления людей паракватом широко известна в Индии. Крестьяне, которые работают на полях, рискуют получить опасную дозу вещества и погибнуть.
Специалисты ДВФУ вместе с российскими и зарубежными коллегами установили, что соединения из морского плесневого гриба Penicillium dimorphosporum могут защитить от воздействия параквата. Эксперимент провели на клеточной линии нейробластомы. По происхождению это опухолевые клетки, на которых изучают нейропротекторную (нейрозащитную) активность потенциальных лекарственных средств.
«В очень малой концентрации, около одного микромоля на литр, найденные соединения увеличивали жизнеспособность клеток, обработанных паракватом, почти на 40 процентов по сравнению с клетками, обработанными только паракватом. В ходе дальнейших исследований мы хотим подробнее выяснить, каким образом эти природные молекулы защищают клетку. Возможно, они действуют как антиоксиданты, и, вероятно, они также могут защитить клетки от других токсичных веществ», – рассказала Олеся Журавлева,